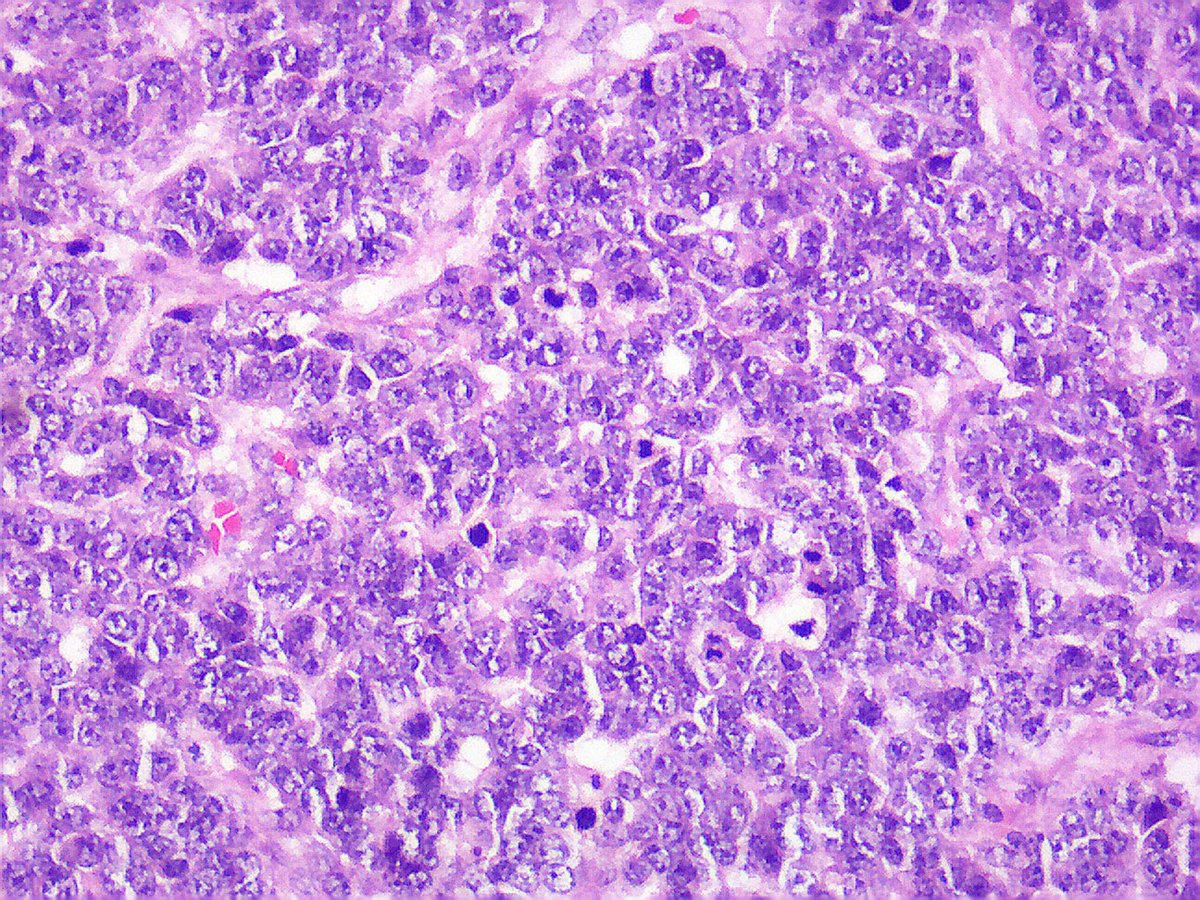

Mantle cell
Ствол тоз 78
Женская стрижка на волнистые волосы фото
День манилова
Чудинова иркутск
По середине плеча
Cos 3 68
Ст сардан
Треш полька эскизы мужские
Как правильно пишется слово выиграть
Тойота венза год выпуска
Как можно подать на детские пособия
Лк сеченовский университет
Атлант мхм 1703
Mantle cell 111 фото